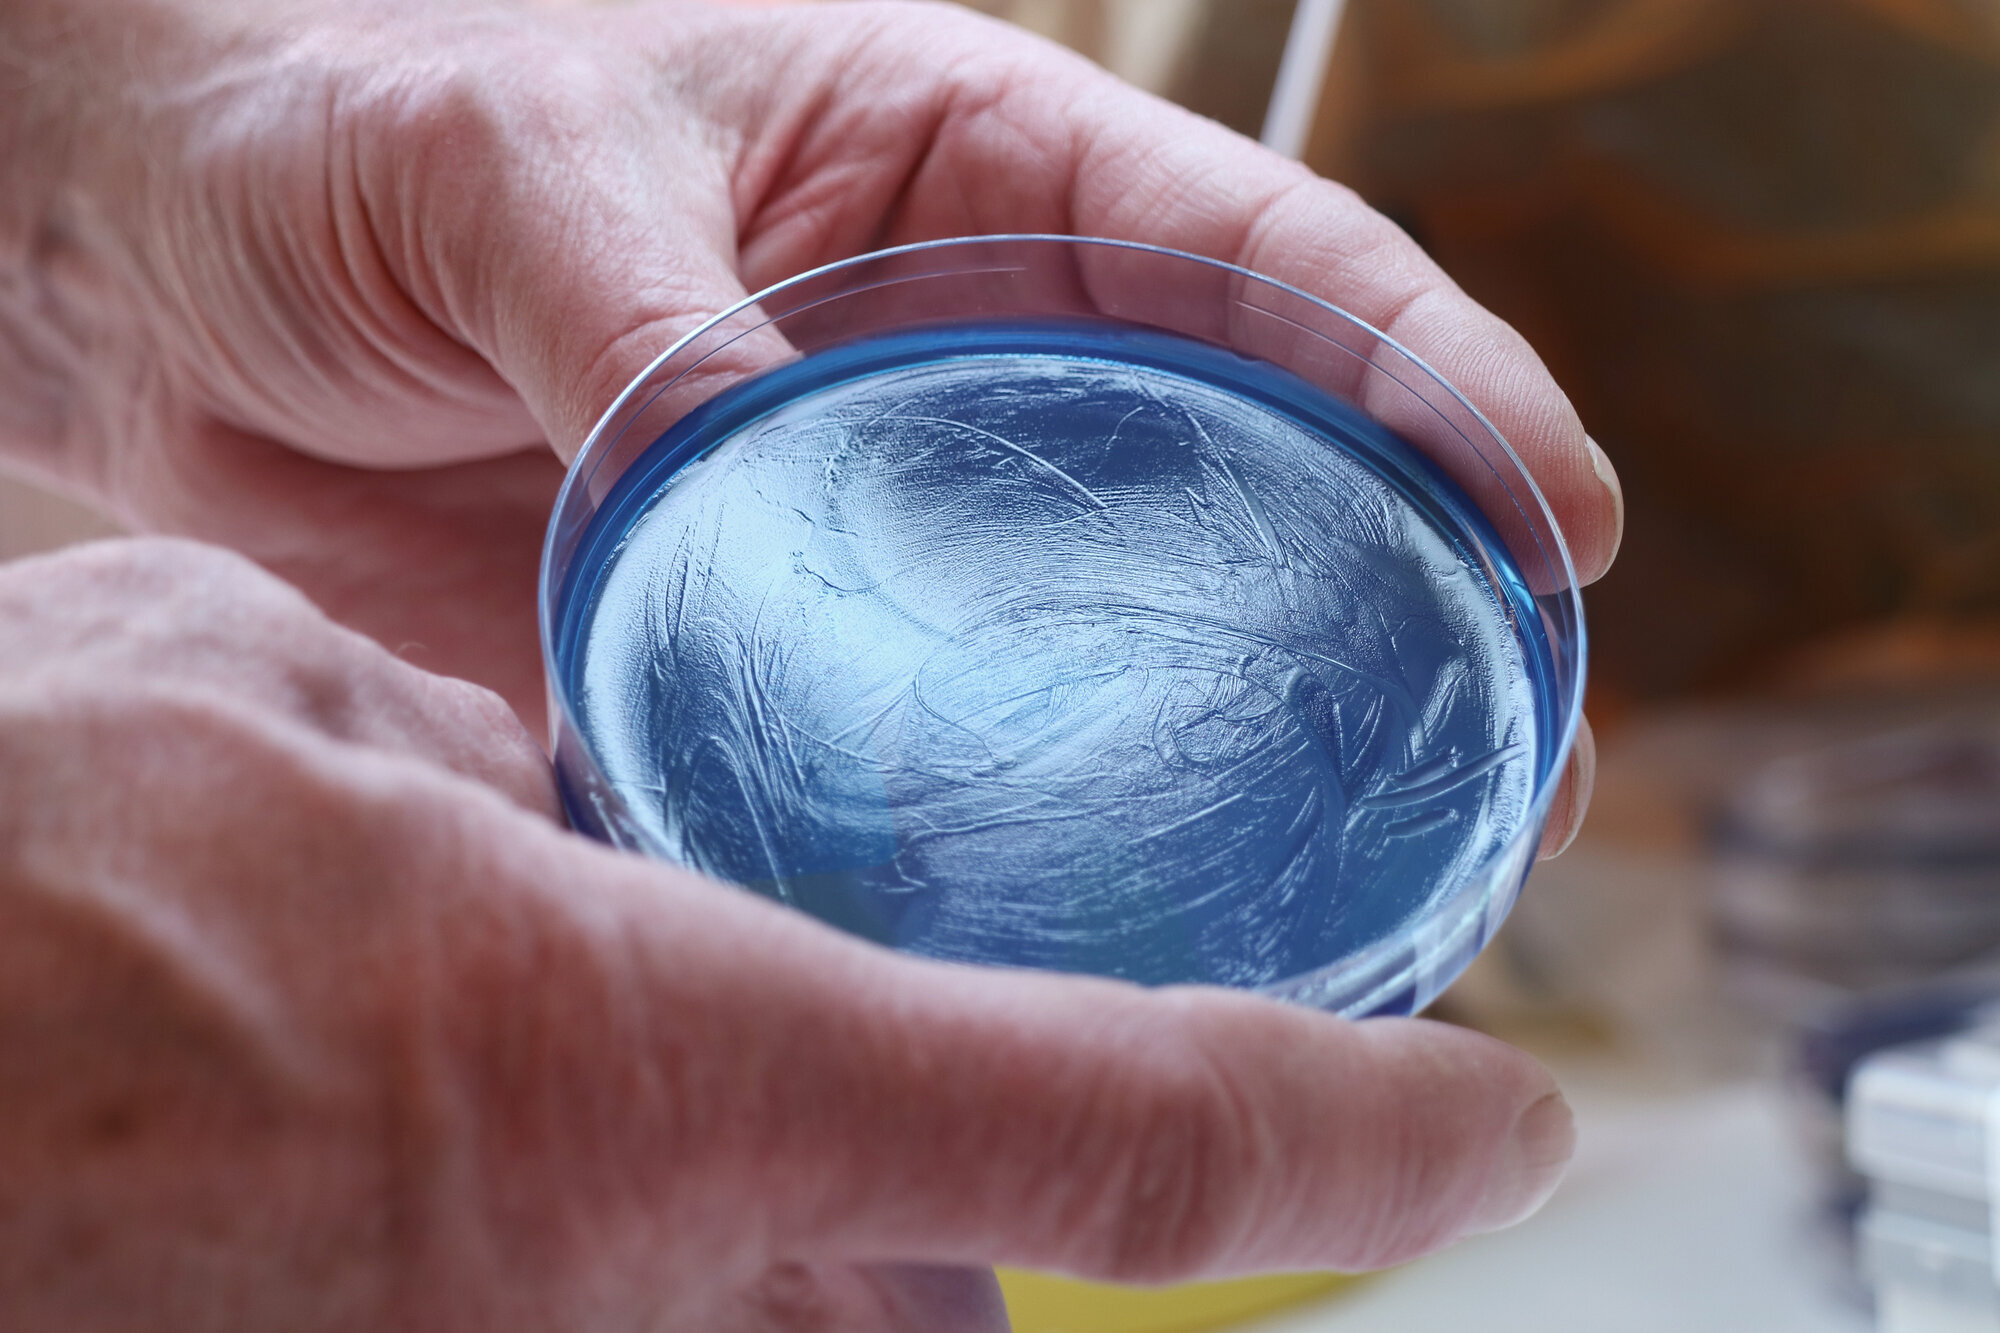
Bildet viser en petriskål med Pseudomonas aeruginosa.

– Nå jobber vi for å finne omfanget av utbruddet
Uten årvåkne klinikere kunne utbruddet med Pseudomonas aeruginosa gått under radaren. Nå er FHI spent på om bakterien bare er i Norge.
– Det er veldig sannsynlig at vi nå har funnet årsaken til utbruddet.
Det sier overlege Bjørn G. Iversen i Folkehelseinstituttet (FHI).
FHI koordinerer en utbruddsgruppe med fagpersoner fra alle helseregionene. Fredag ble det gjort et viktig funn på Oslo universitetssykehus (OUS): Da fant man Pseudomonas aeruginosa i en pakke med vaskekluter av typen Oasis Bedbath. Bakterien er av samme stamme som i det pågående utbruddet med Pseudomonas aeruginosa på norske sykehus.
Mandag ble bakterien funnet i ytterlige åtte pakker, alle fra samme batch.
Rart om det bare er én batch
Alle norske sykehus og kommuner har fått beskjed om umiddelbar stans i bruken av vaskekluten. Samtidig foregår et nitid etterforskningsarbeid.
Produsenten Vernacare er orientert og samarbeider tett med norske myndigheter for å gi informasjonen de etterspør. Vernacare opplyser at de i dag har presentert en handlingsplan for hvilke steg som nå bør tas.
– Nå jobber vi ikke for å finne årsaken til, men omfanget av, utbruddet, sier Bjørn G. Iversen i FHI til Sykepleien.
Så langt er 239 pasienter smittet, på 34 ulike sykehus. Alle fire helseregioner er berørt.
Smittesporerne jobber nå med å få analysert kluter fra så mange ulike batcher som mulig.
En batch er den mengden produkter som er produsert i én omgang.
Ifølge Iversen har produsenten opplyst at den aktuelle batchen kun er sendt til Norge. Produsenten sier til Sykepleien at de nå jobber med å spore hvilket sykehus hver enkelt pakke i denne batchen er sendt til. Det er snakk om 1494 pakker.
– Kan det være at utbruddet er begrenset til én batch?
– Ja, det er mulig. Men det høres rart ut, sier Iversen.
– Pseudomonas-bakterien liker seg i et fuktig miljø, og dersom den har etablert seg i den fuktige delen av produksjonslinjen, er den vanskelig å bli kvitt.

Kan gjemme seg som slim
Iversen var sentral i oppklaringen av Dent-o-sept-saken for tjue år siden. Den gangen var en type munnpensler årsak til et stort utbrudd med Pseudomonas aeruginosa. Her ble bakterien funnet i produksjonsanlegget.
– Jeg vet ikke hvordan vaskeklutene produseres, eller hvor intrikat den fuktige delen av produksjonen er, sier han.
– Men pseudomonas er biofilmdannere, og kan gjemme seg som slim på bortgjemte steder.
Å danne biofilm vil si at bakteriene har evne til å klynge seg sammen, festet til en overflate, og omgi seg med et slags egenprodusert slim. Ved å gjøre dette, øker de sin egen sjanse for å overleve i spesielle miljøer.
– Kunne forblitt uoppdaget
Fuktig utstyr har vært under mistanke i det pågående utbruddet. Derfor har man blant annet gått gjennom alt som har vært brukt til pasienter som er smittet, og forsøkt å finne fellesnevnere.
Antakelsen var først at det måtte være snakk om norsk utstyr, siden det bare er meldt om utbrudd i Norge. Men produsenten av klutene der bakterien ble funnet, er et globalt selskap med hovedkvarter i Storbritannia.
FHI har nå varslet internasjonalt om funnet i de aktuelle vaskeklutene.
– Det er ikke meldt om utbrudd av Pseudomonas areruginosa i andre land?
– Nei, sier Iversen.
– Men dette er en bakterie som sjelden blir genotypet, og utbruddsstammen er ikke veldig resistent.
De fleste laboratorier vil derfor bare svare ut prøvesvar med Pseudomonas aeruginosa, og ikke undersøke av hvilken stamme, med mindre det er snakk om en veldig resistent type.
– Hvordan ble man klar over at det var snakk om et utbrudd?
– Det var fordi man på Universitetssykehuset i Nord-Norge hadde tre pasienter omtrent samtidig, som alle fikk blodbaneinfeksjon med Pseudomonas aeruginosa, forklarer Iversen.
– Det ble det reagert på, og laboratoriet gjorde en såkalt helgenomsekvensering. Det er en møysommelig og dyr analyse, men den viste at de tre pasientene var smittet med samme bakteriestamme.
Denne typen var ikke tidligere beskrevet i Norge eller i andre land.
Da gikk alarmen om at et utbrudd var i gang.
Ifølge Haakon Lindekleiv, medisinsk fagsjef på Universitetssykehuset i Nord-Norge, kunne utbruddet forblitt uoppdaget i lengre tid, dersom det ikke hadde vært for årvåkenheten til de ansatte her.

Spent på utlandet
– Så teoretisk kan det være utbrudd i andre land, men de er ikke erkjent fordi man ikke har gjort en helgenomsekvensering av bakterien?
– Ja. Vi i Norge har nå offentliggjort stammen i den internasjonale gendatabanken, sier Bjørn G. Iversen i FHI.
– Det blir spennende å se om andre land undersøker pseudomonas-tilfeller og om de er av samme stamme.
– Og alle pasientene i det norske utbruddet er smittet i Norge?
– Én kom til sykehus i Norge fra utlandet, med smitte med seg, sier Iversen.
Men han opplyser at dette var en pasient bosatt i Norge.
– Teoretisk kan vedkommende ha vært smittet i Norge før utreise, blitt syk i utlandet og tatt med smitten tilbake igjen, sier Iversen.
– Så dette vet vi ikke.
Kan være flere smittede
FHI vet ikke hvor mange som er berørt. Selv om klutene fra fredag kveld ble tatt ut av bruk i Norge, kan det fremdeles komme flere tilfeller.
Ifølge Bjørn G. Iversen har klutene vært brukt både i intensivavdelinger og i andre avdelinger i sykehus, som sengeposter. FHI vet også at de har vært brukt i kommunale sykehjem.
Produsenten Vernacare understreker overfor Sykepleien at deres produkter er gjennom robuste testprosedyrer, i henhold til internasjonale standarder.
Pseudomonas aeruginosa smitter både gjennom direkte og indirekte kontaktsmitte.
– Vi regner med at de fleste smittetilfellene skyldes smitte direkte fra klutene, sier Iversen.
– Men vi kan ikke utelukke at noen er smittet indirekte, via personalet eller miljøet på avdelingen.
Derfor mener han dette utbruddet er nok en påminnelse om hvor viktig det helt basale smittevernet er.











0 Kommentarer